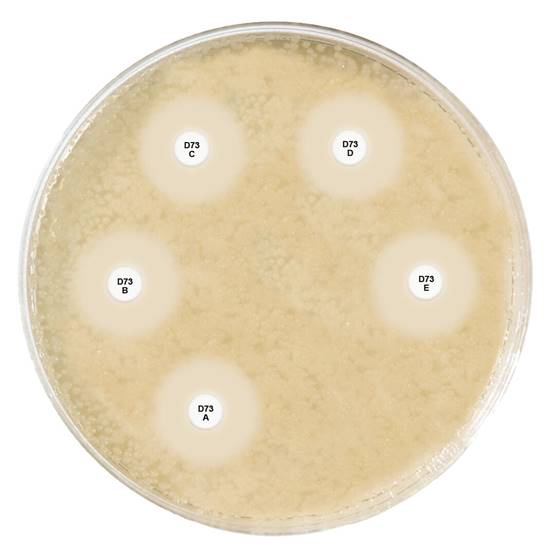

À propos du produit
Détection de la production des enzymes carbapénèmases et OXA-48 chez les entérobactéries.
1 boîte de 5 cartouches, de 50 disques.
Cartouche A : Carbapénème
Cartouche B : Carbapénème + MBL inhibiteur
Cartouche C : Carbapénème + KPC inhibiteur
Cartouche D : Carbapénème + AmpC inhibiteur
Cartouche E : Témocilline + MBL inhibiteur
NB : Créez un compte ou connectez-vous pour télécharger la calculatrice associée à ce produit à partir de l'onglet "Général" ci-dessus.
Produits connexes
CAT-ID Carbapenemase Screening Disc